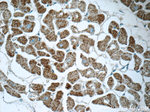
MMADHC Antibody in Immunohistochemistry (Paraffin) (IHC (P))

Search
Proteintech
MMADHC Polyclonal Antibody
{{$productOrderCtrl.translations['antibody.pdp.commerceCard.promotion.promotions']}}
{{$productOrderCtrl.translations['antibody.pdp.commerceCard.promotion.viewpromo']}}
{{$productOrderCtrl.translations['antibody.pdp.commerceCard.promotion.promocode']}}: {{promo.promoCode}} {{promo.promoTitle}} {{promo.promoDescription}}. {{$productOrderCtrl.translations['antibody.pdp.commerceCard.promotion.learnmore']}}
产品信息
23191-1-AP
种属反应
宿主/亚型
分类
类型
抗原
偶联物
形式
浓度
规格
纯化类型
保存液
内含物
保存条件
运输条件
产品详细信息
Immunogen sequence: ESHVAAAPP DICSRTVWPD ETMGPFGPQD QRFQLPGNIG FDCHLNGTAS QKKSLVHKTL PDVLAEPLSS ERHEFVMAQY VNEFQGNDAP VEQEINSAET YFESARVECA IQTCPELLRK DFESLFPEVA NGKLMILTVT QKTKNDMTVW SEEVEIEREV LLEKFINGAK EICYALRAEG YWADFIDPSS GLAFFGPYTN NTLFETDERY RHLGFSVDDL GCCKVIRHSL WGTHVVVGSI FTNATPDSHI MK (41-291 aa encoded by BC022859)
靶标信息
Involved in cobalamin metabolism.
仅用于科研。不用于诊断过程。未经明确授权不得转售。
篇参考文献 (0)
生物信息学
蛋白别名: CblD; Cobalamin trafficking protein CblD; likely ortholog of H. sapiens chromosome 2 open reading frame 25 (C2orf25); methylmalonic aciduria (cobalamin deficiency) cblD type, with homocystinuria; Methylmalonic aciduria and homocystinuria type D homolog, mitochondrial; Methylmalonic aciduria and homocystinuria type D protein, mitochondrial; protein C2orf25, mitochondrial; unnamed protein product
基因别名: 2010311D03Rik; AI314967; C2orf25; cblD; CL25022; HMAD; HSPC161; MACD; MAHCD; MMADHC; My011
UniProt ID: (Human) Q9H3L0, (Mouse) Q99LS1
Entrez Gene ID: (Human) 27249, (Mouse) 109129